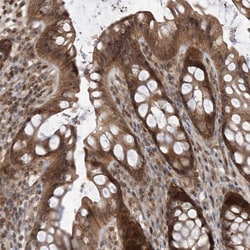
Invitrogen LATS1 Polyclonal Antibody 100 &mu;L; Unconjugated:Antibodies,

missing translation for 'onlineSavingsMsg'
Learn More
Learn More
Invitrogen™ LATS1 Polyclonal Antibody


Rabbit Polyclonal Antibody
Brand: Invitrogen™ PA583209
This item is not returnable.
View return policy
Description
Immunogen sequence: PSWEPNSQTK RYSGNMEYVI SRISPVPPGA WQEGYPPPPL NTSPMNPPNQ GQRGISSVPV GRQPIIMQSS SKFNFPSGRP Highest antigen sequence indentity to the following orthologs: Mouse - 90%, Rat - 96%.
LATS1 is a putative serine/threonine kinase that localizes to the mitotic apparatus and complexes with cell cycle controller CDC2 kinase in early mitosis which is phosphorylated in a cell-cycle dependent manner. The N-terminal region of the protein binds CDC2 to form a complex showing reduced H1 histone kinase activity which indicating a role as a negative regulator of CDC2/cyclin A and the C-terminal kinase domain binds to its own N-terminal region, suggesting potential negative regulation through interference with complex formation via intramolecular binding. LATS1 act as a tumor suppressor and play an important role in the development of soft-tissue sarcomas, ovarian stromal cell tumors and a high sensitivity to carcinogenic treatments.
Specifications
| LATS1 | |
| Polyclonal | |
| Unconjugated | |
| LATS1 | |
| AW208599; h-warts; large tumor suppressor; large tumor suppressor homolog 1; large tumor suppressor kinase 1; large tumor supressor, homolog 1; LATS (large tumor suppressor, Drosophila) homolog 1; LATS, large tumor suppressor, homolog 1; lats1; RGD1564085; Serine/threonine-protein kinase LATS1; WARTS; WARTS protein kinase; wts | |
| Rabbit | |
| Antigen affinity chromatography | |
| RUO | |
| 9113 | |
| Store at 4°C short term. For long term storage, store at -20°C, avoiding freeze/thaw cycles. | |
| Liquid |
| Immunohistochemistry (Paraffin), Western Blot | |
| 0.10 mg/mL | |
| PBS with 40% glycerol and 0.02% sodium azide; pH 7.2 | |
| O95835 | |
| LATS1 | |
| Recombinant protein corresponding to Human LATS1. Recombinant protein control fragment (Product #RP-96529). | |
| 100 μL | |
| Primary | |
| Human | |
| Antibody | |
| IgG |
Product Content Correction
Your input is important to us. Please complete this form to provide feedback related to the content on this product.
Product Title
Spot an opportunity for improvement?Share a Content Correction